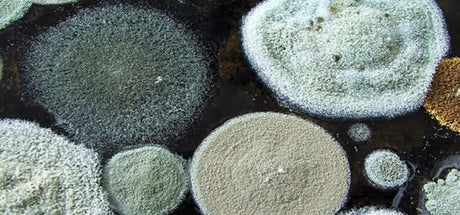
Toxins: Understanding the Risk for Cognitive Decline

Drainage Before Detox - Why Drainage is the First Step to Your Efficient Detoxification
Drainage acts on three levels: cellular, tissue, and organ, preparing an efficient route for toxin elimination. Once the drainage pathways are up and running efficiently, the power of detoxification can be fully realized.